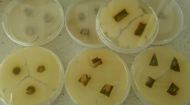
Fragmenty pędów pomidora na szalkach Petriego oraz widoczne wokół wycieki bakteryjne

Choroby bakteryjne w uprawach szklarniowych. Ograniczanie rozwoju chorób w czasie uprawy.
Choroby bakteryjne w uprawach warzyw szklarniowych powodują ogromne straty. W Polsce główne problemy związane są z rakiem bakteryjnym pomidorów wywoływanym przez Clavibacter michiganensis ssp. michiganensis, bakteryjną cętkowatością pomidora wywoływana przez Pseudomonas syringae pv. tomato, chorobą powodującą tak zwaną czarną nóżkę pomidora wywoływaną przez Pectobacterium carotorovorum (dawniej Erwinia carotorovora), oraz groźną w ostatnich latach głównie w uprawach ogórków, ale i pomidorów, chorobą szalonych korzeni, której sprawcą jest Rhiozbium radiobacter lub R. rhizogenes (dawniej Agrobacterium radiobacter lub A. rhizogenes). Według światowej literatury, nie ma w tej chwili skutecznego sposobu leczenia roślin zainfekowanych bakteriami chorobotwórczymi. Walka z tymi chorobami opiera się głównie na profilaktyce i ograniczaniu rozprzestrzeniania się choroby – jeśli już wystąpi

Nadzieja w ECA
Istnieje biobójcza substancja o wysokiej skuteczności działania bakterio-, wiruso- i grzybobójczego, a przy tym działa w bardzo niskim stężeniu. Mowa tu o ECA (Elektro-Chemicznie Aktywowana woda). Substancją aktywną tego środka jest kwas podchlorawy. Ciekawostką jest to, że kwas podchlorawy jest ważnym składnikiem systemu odpornościowego. Wytwarzany jest naturalnie przez białe ciałka krwi ludzi i zwierząt. Kwas podchlorawy jest ważnym składnikiem systemu immunologicznego człowieka. Poza organizmem kwas podchlorawy wytwarzany jest w 100% z naturalnych składników i jest w 100% biodegradowalny. Ma on bardzo wysoki poziom oxydacyjno-redukcyjny – ORP (Redox). Jest to parametr mierzony w miliwoltach. Wynik odzwierciedla aktywność środka odkażającego wodę, a nie poziom jego stężenia. Jest to parametr polecany przez Światową Organizację Zdrowia (WHO) do kontroli biologicznej czystości wody. Według WHO przy ORP Redox na poziomie 650 mV woda jest odkażona a takie bakterie jak E.coli giną w ciągu sekundy. Kwas podchlorawy jest około 100 razy bardziej efektywny niż podchloryn sodu w zwalczania mikroorganizmów (fot. 1).

Można więc zastosować około 100 krotnie mniejsze stężenie substancji aktywnej w stosunku do podchlorynu sodu w celu dokonania skutecznej dezynfekcji. Podobnie wypada porównanie z nadtlenkiem wodoru (tab. 1).
Tab. 1. Porównanie zalecanych dawek substancji aktywnych środków do dezynfekcji linii nawadniających poza uprawą
ECA jest dosyć powszechnie stosowana w Japonii, USA, Kanadzie, gdzie środek ten został dopuszczony do ekologicznej uprawy roślin. W tych krajach ECA jest produkowana głównie na miejscu przez specjalne generatory, gdyż stabilność tej substancji jest bardzo krótka. W ostatnich latach, dzięki opracowaniu technologii stabilizacji kwasu podchlorawego, substancja ta jest coraz powszechniej stosowana do różnych form bezpiecznej dezynfekcji. W Unii Europejskiej kwas podchlorawy został oficjalnie dopuszczony jako środek biobójczy w 2021 roku. Jest on zarejestrowany w wielu krajach, w tym w Polsce, m.in. do dezynfekcji w walce z koronawirusem.
W Polsce jest dostępna ustabilizowana ECA w opakowaniach. Firma Bio ActiW z Dębicy, jako jedna z nielicznych firm na świecie opracowała technologię produkcji i stabilizacji ultra czystego skoncentrowanego kwasu podchlorawego, który ma 12 miesięczny termin przydatności. Produkt jest w 100% biodegradowalny i w 100% wytworzony z naturalnych składników. Do profesjonalnej dezynfekcji w uprawach pod osłonami firma Bio ActiW oferuje produkt: Agro ECA (Bio ActiW 2000) – zarejestrowany produkt do dezynfekcji wody, powierzchni mającej i nie mającej kontaktu z żywnością oraz do dezynfekcji owoców i warzyw po zbiorze (fot. 2). Produkt jest w pełni bezpieczny dla użytkownika. Jest bezpieczny dla skóry, nie wymaga ubrań ochronnych. Dystrybutorem tego produktu w uprawach pod osłonami jest firma Royal Brinkman.

Skuteczność Agro ECA potwierdzona badaniami laboratoryjnymi
Jest bardzo wiele światowych badań potwierdzających dużą skuteczność kwasu podchlorawego w zwalczaniu bakterii, wirusów i grzybów oraz usuwaniu biofilmu. W Polsce firma Bio ActiW zleciła w 2020-21 roku kilkadziesiąt badań w laboratoriach akredytowanych. Badania te potwierdziły wysoką skuteczność produkowanego w Polsce kwasu podchlorawego na wszystkie testowane patogeny: wirusy (w tym koronawirus ludzki), bakterie i grzyby.
Między innymi badania wykonane w marcu 2021 roku na zgodność z normą EN 17272 (dezynfekcja poprzez zamgławianie) wykazały bardzo dużą skuteczność kwasu podchlorawego w zwalczaniu 14 patogenów ( bakterii, grzybów, wirusów, prątków) metodą zamgławiania tzw. suchą mgłą (wielkość kropli poniżej 10 mikronów). Tab. 2
Tab. 2 Wyniki badań zgodnie z normą EN 17272 (dezynfekcja poprzez zamgławianie). Badany produkt: Bio ActiW Protect (15% roztwór Agro ECA). Badanie wykonane w laboratorium Ekolabos w kwietniu 2021 roku.
Podczas tych badań kontrolowany był również poziom chloru w powietrzu. Okazało się, że nie zostało przekroczone tak zwane chwilowe, najwyższe dopuszczalne stężenie chloru w powietrzu. Nie ma więc żadnego ryzyka dla zdrowia ludzi, którzy przebywają w tak dezynfekowanym pomieszczeniu do 30 minut w ciągu dnia. Wyniki tych badań pozwoliły uzyskać rejestracje produktów na bazie kwasu podchlorawego do dezynfekcji hal, biur, a nawet szpitali poprzez zamgławianie suchą mgłą.
Inne badania wykonane również w kwietniu 2021 roku w Instytucie Hodowli i Aklimatyzacji Roślin w Bydgoszczy potwierdziły bardzo wysoką skuteczność kwasu podchlorawego na poziomie ponad 6.0 log (>99,9999%) wobec jednych z najgroźniejszych bakterii w uprawach roślin (tab. 3)
Tab. 3 Wyniki badań zgodnie z normą PN-EN 1276/2010. Badany produkt: 5% roztwór Bio ActiW 2000 (Agro ECA).
Możliwości ograniczenia rozwoju chorób bakteryjnych za pomocą Agro ECA
W 2020 roku Agro Smart Lab przeprowadził testy w jednej ze szklarni, w której wystąpił rak bakteryjny pomidorów. Przez dwa dni dezynfekowano pożywkę Agro ECA w 2,0% stężeniu. Środek podawany był w słoneczny dzień w godzinach przedpołudniowych. Kontrolę stanowiły fragmenty chorej rośliny, które wyłożono na szalce Petriego z podłożem hodowlanym. Po kilku dniach powierzchnia szalek pokryta była wyciekiem bakteryjnym (fot. 4).
Po zastosowaniu Agro ECA ponownie pobrano fragmenty chorej rośliny. Na odcinkach łodygi z dolnej i środkowej części rośliny nie zaobserwowano wycieków bakteryjnych, natomiast w górnej części rośliny, wycieki były nieznaczne (fot. 4 – 5). Nie zaobserwowano żadnych objawów fitotoksycznych na roślinach, którym podawano Agro ECA. Z tych testów wynika, że jest możliwe ograniczenie infekcji bakteryjnych roślin, ale powinno się powtarzać zabiegi co 1-3 tygodni, aby ograniczyć do poziomu nie stanowiącego zagrożenia dla roślin.
Jesienią 2021 roku Agro Smart Lab przetestował skuteczność produktu Agro ECA wobec bakterii wywołującej chorobę szalonych korzeni. W jednej ze szklarni na południu Polski zostały pobrane próbki korzeni pomidora, które wykazywały objawy choroby szalonych korzeni (fot. 6).

Odcinki korzeni zostały wyłożone na szalkę Petriego. Porównano próbę kontrolną, nie traktowaną Agro ECA z próbą spryskaną 1,5% roztworem Agro ECA (30 ppm). Na próbach kontrolnych zaobserwowano wyciek bakterii (fot. 7). W przypadku próby potraktowanej Agro ECA wyciek bakteryjny był znacznie ograniczony (fot. 8). Potwierdziło to działanie kwasu podchlorawego wobec bakterii, nawet przy zastosowaniu niskiego stężenia (30 ppm).
Testy te wykazały możliwość zwalczania bakterii znajdujących się w wełnie mineralnej. Kolejnym etapem było sprawdzenie czy można ograniczyć liczbę bakterii znajdujących się wewnątrz korzeni i czy środek nie wykazuje działań fitotoksycznych przy dezynfekcji pożywki w czasie uprawy. W tym celu część mat było dezynfekowanych 1%, 1,5% oraz 2,5% roztworem Agro ECA przez dwa dni (w słoneczne dni – przed południem).
W żadnym przypadku nie zaobserwowano fitotoksyczności na roślinach pomidorów, a wyniki pierwszych testów ograniczania choroby szalonych korzeni na roślinach wydają się obiecujące. Jednak z powodu kończącego się sezonu uprawy, badania te nie są miarodajne.
Testy te pokazały, że istnieje szansa na opracowanie skutecznej technologii ograniczania chorób bakteryjnych po ich wystąpieniu – przy zastosowaniu ECA do dezynfekcji pożywki. Zwłaszcza, że inne dwuletnie doświadczenia wdrożeniowe z takim użyciem Agro ECA w ograniczaniu Phytophotora cactorum w uprawie truskawek na rynnach w podłożu kokosowym sprawdziło się bardzo dobrze. W przypadku chorób bakteryjnych, konieczne jest jednak przeprowadzenie większej liczby testów wdrożeniowych, które są planowane na początku sezonu w uprawach ogórków.
Lepiej zabezpieczać niż leczyć
Wszyscy zdają sobie sprawę, że najlepszym sposobem zapobiegania wystąpieniu chorób bakteryjnych czy „odglebowych” powodowanych przez grzyby jest właściwa dezynfekcja przed rozpoczęciem uprawy. Skuteczna dezynfekcja szklarni i systemu nawadniania to podstawa.
Usuwanie biofilmu z linii nawadniającej
Badania przeprowadzone w ostatnim dziesięcioleciu wykazały, że większość bakterii, w tym gatunków powiązanych z roślinami, występuje zwykle jako kompleksowe biofilmy. Biofilm jest substancją, która łatwo formuje się w liniach dystrybucji wody, zbiornikach do magazynowania wody i każdym innym środowisku wodnym. Biofilm tworzy się, gdy bakterie zaczynają wydzielać śluzowatą, lepką substancję (matryca polisacharydowa), która pozwala im przylegać do powierzchni. Masa biofilmu zwykle składa się z wielu gatunków bakterii i często może obejmować grzyby, glony i pierwotniaki. Szlam biofilmu zabezpiecza mikroorganizmy wywołujące choroby, chroniąc je przed dezynfekcją (rys. 1)

Niestety, jeszcze powszechnie stosowana dezynfekcja systemów nawadniających kwasem azotowym i podchlorynem sodu jest najczęściej niewystarczająca. Wynika to z tego, że jedno-dwukrotne przepłukanie kwasem azotowym i podchlorynem sodu usunie części mineralne i organiczne oraz wolne komórki bakterii czy grzybów ale nie zawsze usunie biofilm. Podchloryn sodu nie jest bowiem skuteczny w usuwaniu biofilmu.
Skutecznym sposobem dezynfekcji linii nawadniającej wraz z pozbyciem się biofilmu jest w pierwszej kolejności zastosowanie kwasu azotowego do usunięcia części organicznych i mineralnych. W następnym dniu przepłukanie linii i napełnienie jej 2,5% roztworem Agro ECA, który powinien pozostać w instalacji minimum 4-5 godzin.
Agro ECA jest również polecana do dezynfekcji mat uprawowych, które chce się wykorzystać z poprzedniego sezonu. W tym przypadku również stosuje się 2,5% stężenie Agro ECA.
Dezynfekcja szklarni poprzez zamgławianie
Oprócz standardowej dezynfekcji szklarni zaleca się dokonać dezynfekcji poprzez zamgławianie, gdyż wiele patogenów może znajdować się w trudno dostępnych miejscach. Ważne jest tutaj aby zastosować środek, który jest skuteczny i bezpieczny dla człowieka i otoczenia. Kwas podchlorawy spełnia takie wymagania. Agro ECA/Bio ActiW 2000 jest obecnie jedynym preparatem dostępnym dla rolnictwa, które może się pochwalić skutecznością z wymaganiami europejskiej normy: 17272 (dezynfekcja poprzez zamgławianie). Jest to również jedyna substancja która nie zagraża zdrowiu człowieka po wejściu do dezynfekowanego pomieszczenia – w przeciwieństwie do ozonu czy nadtlenku wodoru.

Do dezynfekcji szklarni poprzez zamgławianie można zastosować zamgławiacze termiczne, tak zwane pulsfogi oraz urządzenia które wytwarzają tak zwaną zimną, suchą mgłę (wielkość kropli poniżej 10 mikronów). W przypadku tych ostatnich urządzeń nie jest wymagane stosowania nośnika mgły.
Skuteczna dezynfekcja kwasem podchlorawym, zgodnie z normą EN17272 polega na dostarczeniu 6 ppm kwasu podchlorawego na 1 m3 kubatury i pozostawienie zamkniętego pomieszczenia na kilka godzin.
W przypadku zamgławiaczy termicznych należy zastosować 1,5 litra Agro ECA +3 litry wody + 0,1 litra nośnika mgły VK-2 Special 80ECl lub 0,3 litra gliceryny na 500 m3 objętości szklarni. To jest 3 litry Agro ECA na 1000 m3.
W przypadku urządzeń wytwarzających suchą mgłę za pomocą ultradźwięków należy zastosować 3 litry Agro ECA i 17 litrów wody destylowanej na 1000 m3 obiektu.
Agro ECA może być również stosowana do dezynfekcji obiektów poprzez zamgławianie w obecności roślin. W tym celu w przypadku urządzeń ultradźwiękowych stosuje się 10% roztwór Agro ECA (2,0 litra Agro ECA + 18 litrów wody na 1000 m3 obiektu. W przypadku zamgławiaczy termicznych należy zastosować 1,0 litra Agro ECA +4 litry wody + 0,1 litra nośnika mgły VK-2 Special 80ECl lub 0,3 litra gliceryny na 500 m3 objętości szklarni. To jest 2 litry Agro ECA na 1000 m3.